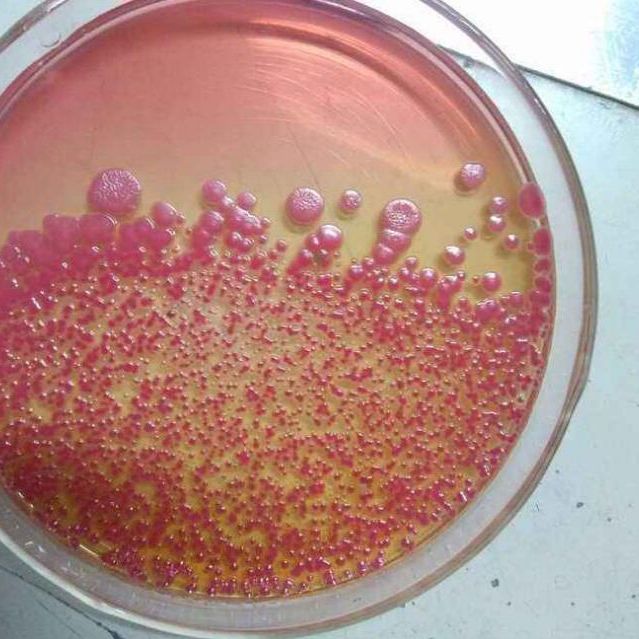
产品封面图

万千商家帮你免费找货
0 人在求购买到急需产品
- 详细信息
- 文献和实验
- 技术资料
- 库存:
50
- 英文名:
Strain Store Medium
- 保质期:
详见说明书
- 供应商:
上海一研
- 保存条件:
低温冷藏
- 规格:
50支/盒
公司提供的培养基品种全面,价格优惠、实验方法、培养基使用说明,均可我们,或咨询在线客服,我们将竭诚为您服务,详情请咨询我们客服专员!
中文名称:瓷珠菌种保存管(50支)
英文名称:Strain Store Medium
产品规格:50支/盒
瓷珠菌种保存管由冷冻管、瓷珠和冷冻保存液组成,主要用于菌种保存、复苏和运输。相对于传统的菌种保藏方法具有明显的优势:
1、操作简单方便:挑取细菌新鲜纯培养物,接入菌种保存管。
2、菌种保存快速:内含天然的多孔瓷珠,有利于细菌的吸附及保存。冷冻保存液使菌株免受溶液和冰晶影响。混匀后,吸出冷冻保存液。
3、包装物体积小:1.8ml冷冻管。
4、菌种保存时间长:特殊材料制成的冷冻管,密封性能及耐低温性能极好。2-8℃可保存6个月;-20℃可保存12个月;-80℃可保存24个月。
【实验方法】
1.培养基阳性组:取稀释后的各试验菌悬液1ml分别加于预先制备的试管培养基中,每种细菌接种两支试管。产品仅限于科研同时分别取1ml菌悬液加于无菌空平皿中,用于计数,每种细菌做两个平板。
2. 培养基阴性组:即空白对照,即不添加菌液。
3. 接种量计数:平皿中,细菌倾注培养基,霉菌和白色念珠菌倾注培养基。同时每种培养基做1个空白。
4. 培养条件:
无菌检查:20~25℃培养14天或直至出现浑浊(不超过14天)
MPN计数:30~35℃培养箱中培养3天
控制菌检查:30~35℃培养箱中培养18~24小时
倾注计数用的的培养基平板置30~35℃培养箱中培养3天
倾注计数用的培养基平板置20~25℃培养箱中培养3~5天
特点:
(1)瓷珠菌种保存管(50支)MS培养基 它是1962年由Murashige和Skoog为培养烟草细胞而设计的。特点是无机盐和离子浓度较高,为较稳定的平衡溶液。其养分的数量和比例较合适,可满足植物的营养和生理需要。它的硝酸盐含量较其他培养基为高,广泛地用于植物的器官、花药、细胞和原生质体培养,效果良好。有些培养基是由它演变而来的。
(2)B5培养基 是1968年由Gamborg等为培养大豆根细胞而设计的。其主要特点是含有较低的铵,这可能对不少培养物的生长有抑制作用。从实践得知有些植物在B5培养基上生长更适宜,如双子叶植物特别是木本植物。
(3)White培养基 是1943年由White为培养番茄根尖而设计的。1963年又作了改良,称作White改良培养基,提高了MgSO4的浓度和增加了鹏素。其特点是无机盐数量较低,适于生根培养。
(4)N6培养基 是1974年朱至清等为水稻等禾谷类作物花药培养而设计的。其特点是成分较简单,KNO3和(NH4)2SO4含量高。在国内已广泛应用于小麦、水稻及其他植物的花药培养和其他组织培养。
(5)KM-80培养基 它是1974年为原生质体培养而设计的。其特点是有机成分较复杂,它包括了所有的单糖和维生素,广泛用于原生质融合的培养。
DECR1线粒体2,4-双烯酰辅酶A还原酶1抗体NFkBp105/p50overexpression293Tlysate(wholecell)
DEC-205/CD205/Ly75淋巴细胞抗原75抗体Hsp60overexpression293Tlysate(wholecell)
DEAF1/DeformedEpidermalAutoregulatoryFactor1畸形表皮自调节因子1抗体IRAKMoverexpression293Tlysate(wholecell)
DDX58DDX58抗体TMS1/ASCoverexpression293Tlysate(wholecell)
DDX53/CT26肿瘤/睾丸抗原26抗体TMS1overexpression293Tlysate(wholecell)
DDX43/CT13肿瘤/睾丸抗原13抗体ICADoverexpression293Tlysate(wholecell)
DDX4/MVHDDX4抗体RIP2overexpression293Tlysate(wholecell)
DDX19B/DBP5解旋酶DEAD5抗体EpCAMoverexpression293Tlysate(wholecell)
DDRGK1DDRGK1蛋白抗体EpCAMoverexpression293Tlysate(wholecell)
DDIT4LDNA损伤诱导转录样蛋白4抗体C1Inactivatoroverexpression293Tlysate(wholecell)
DDIT4/REDD1DNA损伤诱导转录蛋白4抗体OSMRoverexpression293Tlysate(wholecell)
D-DIMER交联纤维蛋白二聚体抗体XPDoverexpression293Tlysate(wholecell)
DDCT/DDTD型多巴色素脱羧酶Cytokeratin4overexpression293Tlysate(wholecell)
DDC/DOPADecarboxylase多巴脱羧酶抗体SMC3overexpression293Tlysate(wholecell)
DDB2DNA损伤结合蛋白2抗体SIRPalphaoverexpression293Tlysate(wholecell)原人参二醇(PPD)Anti-CD3antibody[UCH-T1]
原人参三醇(PPT)Anti-CD45ROantibody[UCH-L1]
泽兰黄酮 Anti-Rbantibody[Rb11F8]
泽泻醇B-23-醋酸酯 Anti-CD35antibody[E11]-BSAandAzidefree
獐芽菜苦苷Anti-p53antibody[PAb240]
芝麻酚Anti-p53antibody[PAb240]
知母皂苷A-ⅢAnti-p53antibody[PAb1801]
知母皂苷元Anti-p53antibody[PAb1801]
竹叶香附素A Anti-PCNAantibody[PC10]
紫草酸Anti-PCNAantibody[PC10]
紫堇灵Anti-EGFRantibody[EGFR1]
紫杉叶素 Anti-EGFRantibody[EGFR1]
紫云英苷 Anti-PKCantibody[MC5]
祖师麻素 Anti-Myctagantibody[9E10]-ChIPGrade
瑞香素 Anti-Myctagantibody[9E10]-ChIPGrade
瓷珠菌种保存管(50支)己酸酯Anti-MBD2+MBD3antibody[106B691]
己酸酯Anti-PPARgammaantibody-ChIPGrade
季四醇四硬脂酸酯Anti-RANKLantibody[12A668]-BSAandAzidefree
2,4-二异酸酯Anti-ADAMTS12antibody
代亚基2,4-二异酸酯Anti-ADAMTS7antibody
磺酸酯Anti-ADAMTS15antibody
基败脂酸烯酯Anti-ADAMTS16antibody
基烯酸-2-羟酯Anti-ESAT6antibody
基烯酸酯Anti-CFP10antibody
基烯酸酯Anti-AndrogenReceptor(phosphoS210+S213)antibody[156C135.2]
基二十八烷酸酯Anti-Psoriasinantibody[47C1068]
酸苄酯Anti-TLR3antibody[40C1285.6](Phycoerythrin)
酸酯Anti-TLR8antibody[44C143](Phycoerythrin)
酸异酯Anti-CDCA2antibody
酸正酯Anti-Hsp70antibody[EP1007Y]Stain-All 20mg
CCK8新的饱食分子蛋白抗体
CCR-1脊髓灰质炎病毒受体相关蛋白4抗体
CCR-2细胞毒性受体NK-p80抗体
CCR3细胞粘附分子CD112抗体
CCR4肾小球细胞粘附分子受体抗体
Caspase-3成纤维细胞核受体Nr5a2抗体
Collagen VI alpha 1钠钙交换蛋白1抗体
Caspase 8钠钙交换蛋白3抗体
【操作步骤】
(一)准确称量试剂:根据不同的菌类和用途,选择适宜的培养基,培养基所需试剂必须纯净。
(二)校正pH值:将称量好的培养基各种成分放入容器内,标记划线,加热溶解,补充水分,测定酸碱度,常用pH6.8~8.0的精密试纸或酸度计测定。用1N NaOH和1N HCl调节pH值到适宜范围内。
(三)过滤:产品仅限于科研将玻璃漏斗置铁架上,再用纱布夹棉花或用滤纸放在漏斗中,将上述培养基倒入其中过滤至透明。
(四)分装:将过滤后的培养基分装于中试管或三角瓶内(试管内每支装5mL;三角瓶中装100~150ml),塞好棉塞用牛皮纸包扎好,准备灭菌。
(五)灭菌:培养基的灭菌,常用高压蒸汽灭菌法。一般微生物的营养细胞在水中煮沸后即被杀死,但细菌的芽胞有较强的抗热性,须经高压蒸汽灭菌才能达到彻底灭菌的目的。根据蒸汽温度随压力升高而上升的原理,即压力越大,蒸汽温度就越高。因此,在同一温度条件下,采用高压蒸汽灭菌比干热灭菌法效果要好。而且在湿热情况下,菌体吸收水分后,其蛋白质易于凝固变性,因为蒸汽的穿透力强,杀菌效果好。
中文名称:瓷珠菌种保存管(50支)
英文名称:Strain Store Medium
产品规格:50支/盒
瓷珠菌种保存管由冷冻管、瓷珠和冷冻保存液组成,主要用于菌种保存、复苏和运输。相对于传统的菌种保藏方法具有明显的优势:
1、操作简单方便:挑取细菌新鲜纯培养物,接入菌种保存管。
2、菌种保存快速:内含天然的多孔瓷珠,有利于细菌的吸附及保存。冷冻保存液使菌株免受溶液和冰晶影响。混匀后,吸出冷冻保存液。
3、包装物体积小:1.8ml冷冻管。
4、菌种保存时间长:特殊材料制成的冷冻管,密封性能及耐低温性能极好。2-8℃可保存6个月;-20℃可保存12个月;-80℃可保存24个月。
【实验方法】
1.培养基阳性组:取稀释后的各试验菌悬液1ml分别加于预先制备的试管培养基中,每种细菌接种两支试管。产品仅限于科研同时分别取1ml菌悬液加于无菌空平皿中,用于计数,每种细菌做两个平板。
2. 培养基阴性组:即空白对照,即不添加菌液。
3. 接种量计数:平皿中,细菌倾注培养基,霉菌和白色念珠菌倾注培养基。同时每种培养基做1个空白。
4. 培养条件:
无菌检查:20~25℃培养14天或直至出现浑浊(不超过14天)
MPN计数:30~35℃培养箱中培养3天
控制菌检查:30~35℃培养箱中培养18~24小时
倾注计数用的的培养基平板置30~35℃培养箱中培养3天
倾注计数用的培养基平板置20~25℃培养箱中培养3~5天
特点:
(1)瓷珠菌种保存管(50支)MS培养基 它是1962年由Murashige和Skoog为培养烟草细胞而设计的。特点是无机盐和离子浓度较高,为较稳定的平衡溶液。其养分的数量和比例较合适,可满足植物的营养和生理需要。它的硝酸盐含量较其他培养基为高,广泛地用于植物的器官、花药、细胞和原生质体培养,效果良好。有些培养基是由它演变而来的。
(2)B5培养基 是1968年由Gamborg等为培养大豆根细胞而设计的。其主要特点是含有较低的铵,这可能对不少培养物的生长有抑制作用。从实践得知有些植物在B5培养基上生长更适宜,如双子叶植物特别是木本植物。
(3)White培养基 是1943年由White为培养番茄根尖而设计的。1963年又作了改良,称作White改良培养基,提高了MgSO4的浓度和增加了鹏素。其特点是无机盐数量较低,适于生根培养。
(4)N6培养基 是1974年朱至清等为水稻等禾谷类作物花药培养而设计的。其特点是成分较简单,KNO3和(NH4)2SO4含量高。在国内已广泛应用于小麦、水稻及其他植物的花药培养和其他组织培养。
(5)KM-80培养基 它是1974年为原生质体培养而设计的。其特点是有机成分较复杂,它包括了所有的单糖和维生素,广泛用于原生质融合的培养。
DECR1线粒体2,4-双烯酰辅酶A还原酶1抗体NFkBp105/p50overexpression293Tlysate(wholecell)
DEC-205/CD205/Ly75淋巴细胞抗原75抗体Hsp60overexpression293Tlysate(wholecell)
DEAF1/DeformedEpidermalAutoregulatoryFactor1畸形表皮自调节因子1抗体IRAKMoverexpression293Tlysate(wholecell)
DDX58DDX58抗体TMS1/ASCoverexpression293Tlysate(wholecell)
DDX53/CT26肿瘤/睾丸抗原26抗体TMS1overexpression293Tlysate(wholecell)
DDX43/CT13肿瘤/睾丸抗原13抗体ICADoverexpression293Tlysate(wholecell)
DDX4/MVHDDX4抗体RIP2overexpression293Tlysate(wholecell)
DDX19B/DBP5解旋酶DEAD5抗体EpCAMoverexpression293Tlysate(wholecell)
DDRGK1DDRGK1蛋白抗体EpCAMoverexpression293Tlysate(wholecell)
DDIT4LDNA损伤诱导转录样蛋白4抗体C1Inactivatoroverexpression293Tlysate(wholecell)
DDIT4/REDD1DNA损伤诱导转录蛋白4抗体OSMRoverexpression293Tlysate(wholecell)
D-DIMER交联纤维蛋白二聚体抗体XPDoverexpression293Tlysate(wholecell)
DDCT/DDTD型多巴色素脱羧酶Cytokeratin4overexpression293Tlysate(wholecell)
DDC/DOPADecarboxylase多巴脱羧酶抗体SMC3overexpression293Tlysate(wholecell)
DDB2DNA损伤结合蛋白2抗体SIRPalphaoverexpression293Tlysate(wholecell)原人参二醇(PPD)Anti-CD3antibody[UCH-T1]
原人参三醇(PPT)Anti-CD45ROantibody[UCH-L1]
泽兰黄酮 Anti-Rbantibody[Rb11F8]
泽泻醇B-23-醋酸酯 Anti-CD35antibody[E11]-BSAandAzidefree
獐芽菜苦苷Anti-p53antibody[PAb240]
芝麻酚Anti-p53antibody[PAb240]
知母皂苷A-ⅢAnti-p53antibody[PAb1801]
知母皂苷元Anti-p53antibody[PAb1801]
竹叶香附素A Anti-PCNAantibody[PC10]
紫草酸Anti-PCNAantibody[PC10]
紫堇灵Anti-EGFRantibody[EGFR1]
紫杉叶素 Anti-EGFRantibody[EGFR1]
紫云英苷 Anti-PKCantibody[MC5]
祖师麻素 Anti-Myctagantibody[9E10]-ChIPGrade
瑞香素 Anti-Myctagantibody[9E10]-ChIPGrade
瓷珠菌种保存管(50支)己酸酯Anti-MBD2+MBD3antibody[106B691]
己酸酯Anti-PPARgammaantibody-ChIPGrade
季四醇四硬脂酸酯Anti-RANKLantibody[12A668]-BSAandAzidefree
2,4-二异酸酯Anti-ADAMTS12antibody
代亚基2,4-二异酸酯Anti-ADAMTS7antibody
磺酸酯Anti-ADAMTS15antibody
基败脂酸烯酯Anti-ADAMTS16antibody
基烯酸-2-羟酯Anti-ESAT6antibody
基烯酸酯Anti-CFP10antibody
基烯酸酯Anti-AndrogenReceptor(phosphoS210+S213)antibody[156C135.2]
基二十八烷酸酯Anti-Psoriasinantibody[47C1068]
酸苄酯Anti-TLR3antibody[40C1285.6](Phycoerythrin)
酸酯Anti-TLR8antibody[44C143](Phycoerythrin)
酸异酯Anti-CDCA2antibody
酸正酯Anti-Hsp70antibody[EP1007Y]Stain-All 20mg
CCK8新的饱食分子蛋白抗体
CCR-1脊髓灰质炎病毒受体相关蛋白4抗体
CCR-2细胞毒性受体NK-p80抗体
CCR3细胞粘附分子CD112抗体
CCR4肾小球细胞粘附分子受体抗体
Caspase-3成纤维细胞核受体Nr5a2抗体
Collagen VI alpha 1钠钙交换蛋白1抗体
Caspase 8钠钙交换蛋白3抗体
【操作步骤】
(一)准确称量试剂:根据不同的菌类和用途,选择适宜的培养基,培养基所需试剂必须纯净。
(二)校正pH值:将称量好的培养基各种成分放入容器内,标记划线,加热溶解,补充水分,测定酸碱度,常用pH6.8~8.0的精密试纸或酸度计测定。用1N NaOH和1N HCl调节pH值到适宜范围内。
(三)过滤:产品仅限于科研将玻璃漏斗置铁架上,再用纱布夹棉花或用滤纸放在漏斗中,将上述培养基倒入其中过滤至透明。
(四)分装:将过滤后的培养基分装于中试管或三角瓶内(试管内每支装5mL;三角瓶中装100~150ml),塞好棉塞用牛皮纸包扎好,准备灭菌。
(五)灭菌:培养基的灭菌,常用高压蒸汽灭菌法。一般微生物的营养细胞在水中煮沸后即被杀死,但细菌的芽胞有较强的抗热性,须经高压蒸汽灭菌才能达到彻底灭菌的目的。根据蒸汽温度随压力升高而上升的原理,即压力越大,蒸汽温度就越高。因此,在同一温度条件下,采用高压蒸汽灭菌比干热灭菌法效果要好。而且在湿热情况下,菌体吸收水分后,其蛋白质易于凝固变性,因为蒸汽的穿透力强,杀菌效果好。
风险提示:丁香通仅作为第三方平台,为商家信息发布提供平台空间。用户咨询产品时请注意保护个人信息及财产安全,合理判断,谨慎选购商品,商家和用户对交易行为负责。对于医疗器械类产品,请先查证核实企业经营资质和医疗器械产品注册证情况。
文献和实验相关实验
1 设备与材料1.1 低温冰箱:-70℃1.2 高压灭菌器。1.3 多孔玻璃珠(或素烧瓷珠):直径2~3 mm。1.4 商业化细胞冻存管(可选)。 2 操作步骤2.1 将直径为2-3 mm 的瓷珠分装到小螺旋帽瓶中(每瓶最多装30 粒)制成冷冻管,高压灭菌。2.2 标记冷冻管。2.3 在无菌状态下打开冷冻管。2.4 在所保藏菌种的最适营养条件下将细胞培养至稳定期或成熟期,进行纯度检查后,将菌株新鲜培养物加入到培养基中制成混悬液,无菌操作将混悬液转入到冷冻管中。2.5 封好冷冻管并颠倒四
管。 2.3 接种针。 2.4 显微镜。 2.5 超净工作台。 2.6 玻片、酒精灯、洗耳球、试管架。 2.7 天平:感量0.01g。 2.8 灭菌釜。 2.9 培养皿(直径为90mm)、试管,经121℃、30分钟灭菌。 2.10试管夹、酒精灯、秒表、载玻片 3.培养基及试剂: 3.1 乳糖胆盐发酵管:按照制造厂家使用说明进行配制,灭菌。 3.2
技术资料暂无技术资料 索取技术资料
瓷珠菌种保存管(50支)厂家
询价